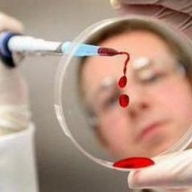
7   228

Количество больных на ВИЧ растет с каждым днем
В Днепропетровске только в этом году у 1,5 тыс. детей обнаружили ВИЧ. Во время тестирования инфекцию также обнаружили у 228 беременных, 7 призывников и 83 доноров.
"Днепропетровская область остается на высоком уровне по заболеваемости СПИДом. С начала года было протестировано более 190 тыс. человек на ВИЧ, из них выявилось ВИЧ-позитивными 3,5 тыс.", – сообщает со ссылкой на главврача центра по профилактике и борьбе со СПИДом Ирину Чухалову издание "Лица".
На данный момент в области антиретровирусную терапию получат 9,5 тыс. человек. 56,2% больных заразились половым путем, 25% – через кровь. Как отмечает медик, на данный момент растет количество детей, которые заразились ВИЧ от матерей. Так, только за прошедший год в регионе родилось 382 ребенка с инфекцией.
К слову, как отмечают медики, средний возраст смерти ВИЧ-пациентов резко вырос по сравнению с 1987 годом.
Источник: Сегодня
Категории: Новости Днепропетровска
01.12.2015 09:08